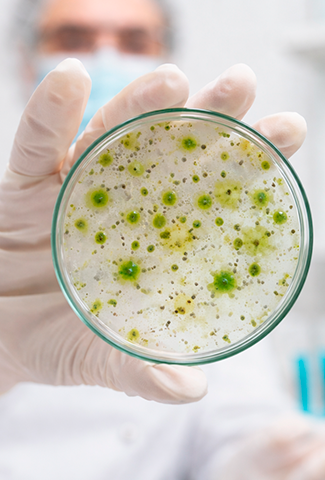

- insuma@insumabiotec.com.br
INSUMA Biotecnologia
Ciência aplicada que transforma microalgas em soluções sustentáveis
QUEM SOMOS
Conhecimento científico, inovação tecnológica e impacto positivo no campo
Por meio de ciência aplicada, utilizamos microalgas como fonte de moléculas naturais de alto valor agregado com foco em aplicações de alto desempenho para o agronegócio e indústria.

Desenvolvimento de bioestimulantes de microalgas voltados ao desempenho fisiológico das plantas.
Produção de compostos bioativos como aminoácidos, proteínas, carotenoides e ácidos graxos para diferentes aplicações industriais.
Desenvolvimento de processos, otimização de cultivos e soluções personalizadas para empresas e instituições.
SOLUÇÃO EM DESTAQUE
Bioestimulante de Microalgas
Produtores rurais, agrônomos, empresas do agronegócio e instituições de pesquisa.
Microalgas ricas em aminoácidos, carbono orgânico, macro e micronutrientes e hormônios vegetais naturais.
· Maior vigor vegetativo
· Desenvolvimento radicular mais eficiente
· Contribuição para a produtividade
· Maior tolerância a estresses
A aplicação é definida conforme cultura, solo e manejo
RESULTADOS
Buscamos constantemente validar nossas soluções em diferentes culturas, climas e tipos de solo.
· Germinação até 3x mais rápida
· Desenvolvimento radicular até 8x superior em comparação a insumos químicos convencionais
· Floração antecipada em lavouras de café
· Maior vigor vegetativo
· Copa e sistema radicular mais desenvolvidos

COMO TRABALHAMOS
Cada projeto é conduzido com metodologia científica e acompanhamento técnico especializado
DIFERENCIAIS
SUSTENTABILIDADE
Fome Zero e Agricultura Sustentáve
Indústria, Inovação e Infraestrutura
Consumo e Produção Responsáveis
Ação Contra a Mudança Global do Clima
INOVAÇÃO & RECONHECIMENTO
Crescimento apoiado por ciência, fomento e ecossistema de inovação.
Constituição jurídica da INSUMA e aprovação do PIPE FAPESP – Fase 1, com incubação na Incubadora de Empresas de Araraquara (SP)
1º lugar no Programa Municipal de Apoio às Startups e ao Empreendedorismo Inovador
Aprovação do PIPE FAPESP – Fase 2 e do Catalisa Sebrae – Fase Validar, viabilizando a expansão da infraestrutura, a profissionalização das operações e a consolidação do MVP
• PIPE FAPESP – Fase 1 (2023)
• Programa Municipal de Apoio às Startups (2023–2024)
• PIPE FAPESP – Fase 2 (2025)
• Catalisa Sebrae – Mobilizar e Aprender (2024)
• Catalisa Sebrae – Validar (2025)
A INSUMA participa de programas que fortalecem sua governança, estratégia e capacidade de escalar soluções científicas.
• PIPE Empreendedor (FAPESP)
• Atômica (Wylinka)
• Start (Abstartups)
• Start Deep Tech (Sebrae for Startups)
• Acelera (APTA Hub)
• Speed Agro (Sebrae for Startups)
Público-alvo
PARA QUEM DESENVOLVEMOS SOLUÇÕES
EQUIPE
A INSUMA é formada por uma equipe com sólida formação científica e experiência em inovação tecnológica.

Fundadora e Diretora Executiva

Coordenadora de PD&I

Responsável Técnica

Gestora de Projetos e Inovação

Especialista em Química Verde

Analista de Negócios
CONTATO
Fale com nossos especialistas

- Av. Jorge Fernandes Mattos, 311
- Box 12B, 8º Distrito Industrial
- Araraquara – SP | CEP: 14808-162
- insuma@insumabiotec.com.br
